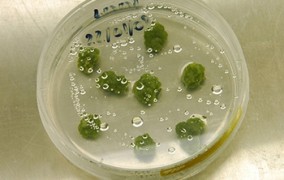

Oportunidades - Bolsas FAPESP
-
Programa BIOTA-FAPESP abre vaga de pós-doutorado em educação
02 de abril de 2020Bolsista participará de pesquisa que analisa o entendimento dos jovens sobre a diversidade e evolução biológica em diferentes regiões do Brasil -
Pós-doutorado em biologia molecular e bioinformática no Instituto de Botânica
02 de abril de 2020Projeto desenvolve análise de dados de sequenciamento em larga escala de genoma e transcritoma de plantas -
Pós-doutorado em bioquímica de oxidantes e radicais na USP
01 de abril de 2020Bolsista vai estudar as ligações cruzadas de proteínas produzidas por processos oxidativos in vitro e em amostras biológicas no Centro de Pesquisa em Processos Redox em Biomedicina -
Vagas de pós-doutorado em engenharia e física
01 de abril de 2020Projeto que investiga estruturas periódicas no contexto de materiais fonônicos e metamateriais acústicos e elásticos dispõe de duas oportunidades de bolsa com atividades na Unicamp -
Pós-doutorado em biologia molecular do câncer na Unicamp
31 de março de 2020Candidato aprovado participará de subprojeto que fará análise de genes associados à resistência à cisplatina em células de câncer de pulmão -
Pós-doutorado em restauração florestal na Esalq-USP
31 de março de 2020Bolsista participará de projeto que busca explorar o potencial das florestas restauradas no Estado de São Paulo -
Pós-doutorado em fotomedicina e fotobiologia na USP de Ribeirão Preto
30 de março de 2020Bolsista participará de estudo sobre o efeito dos processos fotodinâmicos a partir da interação de fármaco fotossensibilizador nanoestruturado em câncer de glioblastoma multiforme -
Treinamento técnico em neurodesenvolvimento na Faculdade de Medicina da USP
30 de março de 2020Candidato deve ter graduação superior em enfermagem, ciências biológicas, biomedicina ou áreas correlatas; inscrições até 9 de abril -
Pós-doutorado em saúde do trabalhador na Faculdade de Saúde Pública da USP
27 de março de 2020Bolsista participará de projeto que estuda a atividade de prevenção de riscos profissionais em empresas públicas e privadas do Estado de São Paulo -
Centro de Pesquisa, Inovação e Difusão em Neuromatemática tem vagas de pós-doutorado
27 de março de 2020Oportunidades oferecidas por CEPID da FAPESP estão direcionadas preferencialmente a candidatos com formação em teoria das probabilidades, neurociência ou engenharia -
Pós-doutorado em acarologia no Instituto Biológico
26 de março de 2020Bolsista vai estudar mecanismos bioquímicos e moleculares de interação entre ácaros predadores, ácaros-praga e plantas hospedeiras -
PD em engenharia de reservatórios no Centro de Pesquisa em Engenharia em Produção de Energia
26 de março de 2020Bolsista trabalhará em pesquisa no EPIC, um CPE constituído pela FAPESP em parceria com a Equinor Brasil Energia -
Pós-doutorado em metabolismo e bioenergética na Unicamp
25 de março de 2020Bolsista participará de projeto que investiga os danos oxidativos e alterações morfológicas nas mitocôndrias relacionadas ao envelhecimento no encéfalo de camundongos -
Treinamento técnico em ciência da computação em empresa com apoio do PIPE
25 de março de 2020São duas vagas em projeto que desenvolve uma plataforma tecnológica de educação corporativa utilizando simuladores 3D -
Pós-doutorado em câncer de cabeça e pescoço no A.C. Camargo
24 de março de 2020Bolsista participará da análise das características epidemiológicas de pacientes na América do Sul e na Europa -
Treinamento técnico em TI aplicada à produção de biocombustíveis avançados
24 de março de 2020Projeto conduzido no Laboratório Nacional de Biorrenováveis do CNPEM explora as sinergias existentes para a integração da produção de biomassa -
Mestrado em análise de imagens de sementes e plântulas na USP
23 de março de 2020Vaga está vinculada ao subprojeto “Relação da fluorescência de clorofila na germinação com o potencial fisiológico de sementes de soja”; inscrições até 31 de março -
Pós-doutorado em política científica e tecnológica na Unicamp
23 de março de 2020São cinco vagas disponíveis em áreas como inovação em sistemas, avanços tecnológicos e convergência tecnológica e ecossistemas de inovação e empreendedorismo -
Pós-doutorado em jornalismo científico no A.C.Camargo
20 de março de 2020Bolsista vai integrar projeto que investiga fatores de risco para o câncer de cabeça e pescoço na América do Sul e na Europa -
Projeto Temático oferece quatro vagas de pós-doutorado em catálise heterogênea
20 de março de 2020Bolsistas vão atuar na Unicamp, na UFSCar e na Embrapa de São Carlos. Objetivo é desenvolver rotas alternativas para converter metano e gás carbônico em metanol -
Doutorado direto em recuperação de informações na Unesp de Rio Claro
20 de março de 2020Pesquisa está relacionada ao uso de estratégias baseadas em ranqueamento e aprendizado não supervisionado para tarefas de classificação -
Instituto Sul-Americano para Pesquisa Fundamental abre vaga de treinamento técnico
19 de março de 2020Bolsista trabalhará na implantação de um sistema para gerenciamento e controle das ações realizadas pelo centro de pesquisa; inscrições até 31 de março -
Pós-doutorado em engenharia bioquímica na USP
19 de março de 2020Projeto conduzido na Escola de Engenharia de Lorena visa desenvolver o conceito de biorrefinaria integrada, aproveitando sinergias entre os processos de produção do etanol e do biodiesel -
Pós-doutorado em desenvolvimento de fármacos para doenças tropicais
18 de março de 2020Consórcio internacional dedicado a pesquisar drogas contra Chagas, leishmaniose e malária oferece quatro bolsas na Unicamp e duas na USP de São Carlos. Inscrições até 30 de março -
Doutorado direto em desenvolvimento de vacinas na USP
18 de março de 2020Três vagas estão disponíveis na Faculdade de Medicina. Projeto propõe uso de partículas semelhantes a vírus para criar imunizantes contra os patógenos chikungunya e Streptococcus pyogenes -
Pós-doutorado em neurobiologia na USP
17 de março de 2020Projeto conduzido no Instituto de Ciências Biomédicas investiga vias neurais em busca de biomarcadores para ansiedade. Inscrições até dia 30 de março -
Pós-doutorado em fisiologia e biologia molecular na Unicamp
17 de março de 2020Duas bolsas são oferecidas pelo Centro de Pesquisas em Obesidade e Comorbidades; inscrições até 27 de março -
Pós-doutorado em dinâmica não linear na USP
16 de março de 2020Projeto conduzido no Instituto de Física estuda a sincronização e a plasticidade de sistemas neurais; inscrições até 25 de março -
Pós-doutorados em ecologia de peixes e sistemas socioambientais
16 de março de 2020Dois bolsistas serão selecionados para projeto da Unicamp que investiga, após uma década, os impactos da construção das hidrelétricas de Belo Monte, Santo Antônio e Jirau na Amazônia -
Pós-doutorado em câncer de cabeça e pescoço no A.C. Camargo
13 de março de 2020Bolsista participará de projeto que investiga os principais fatores de risco na América do Sul e na Europa com o objetivo de melhorar o prognóstico da doença -
Treinamento técnico em fisiologia celular na Universidade Cruzeiro do Sul
13 de março de 2020Os candidatos devem ter graduação na área da saúde ou química. Inscrições até 20 de março -
Centro de Pesquisa em Obesidade e Comorbidades abre vagas de doutorado e pós-doutorado
12 de março de 2020São quatro oportunidades, nas áreas de Sinalização Celular, Neurociência e Imunologia. As inscrições devem ser feitas até dia 20 de março -
Pós-doutorado em reatividade e catálise em nanofios metálicos na Unicamp
12 de março de 2020Projeto envolve cálculos eletrônicos e de transporte, usando metodologias DFT e dinâmica molecular -
Treinamento técnico em Ciência da Informação para Museologia
11 de março de 2020Projeto tem como objetivo principal ampliar e qualificar os processos de comunicação e educação dos museus e demais instituições que recebem público visitante -
Centro de Pesquisas em Alimentos abre vaga de treinamento técnico
11 de março de 2020Bolsista participará do projeto de pesquisa que faz análises térmica e isotermas de sorção de sistemas alimentares complexos de origem vegetal -
Centro de Toxinas, Resposta-Imune e Sinalização Celular abre vaga de pós-doutorado
10 de março de 2020Oportunidade está disponível para candidatos que tenham conhecimento e experiência em síntese de compostos orgânicos, planejamento e execução de reações químicas, purificação de intermediários e produtos finais -
Treinamento técnico em sistemas de produção sustentáveis na Embrapa
10 de março de 2020Vaga disponível em projeto que estuda a termorregulação corpórea de bovinos de corte em sistemas de integração lavoura-pecuária-floresta. As atividades serão exercidas em São Carlos -
Duas vagas de pós-doutorado em Hematologia no Hemocentro da Unicamp
09 de março de 2020Bolsistas vão participar de projeto que analisa os mecanismos de ação de compostos que modulam as alterações epigenéticas e metabolismo energético nas síndromes mielodisplásicas e leucêmicas -
Treinamento técnico em Modelagem de Biorrefinarias no CNPEM
09 de março de 2020Candidato selecionado trabalhará com banco de dados e softwares em projeto sobre biocombustíveis avançados, que tem cooperação com instituições de pesquisa e tecnologia da Comunidade Europeia -
Pós-doutorado em agronomia na Unicamp
06 de março de 2020Projeto conduzido no Núcleo Interdisciplinar de Planejamento Energético visa apoiar o programa brasileiro de agricultura de baixo carbono -
Treinamento técnico em tecnologia da informação
06 de março de 2020Bolsista vai atuar na caracterização de detector e de instrumentação para tomografia por emissão de pósitron; vaga é oferecida pela empresa Gaugit, apoiada pela FAPESP -
Mestrado em aquicultura na Esalq-USP
05 de março de 2020Candidato deve ter graduação em agronomia, zootecnia ou áreas correlatas. Também é desejável experiência com formulação e fabricação de rações para organismos aquáticos -
Vagas de pós-doutorado em nanomateriais são oferecidas no LNNano e na UFABC
05 de março de 2020Dois bolsistas serão selecionados para projeto que estuda as simulações computacionais das interfaces de materiais em 2D e com perovskitas híbridas -
Treinamento técnico em ciência da computação
04 de março de 2020Bolsista trabalhará em empresa que recebe apoio do Programa Pesquisa Inovativa em Pequenas Empresas na área de banco de dados e mapeamento de buscas para links patrocinados de aplicativo móvel -
Pós-doutorado em terapia celular
04 de março de 2020Três vagas disponíveis em Centro de Pesquisa, Inovação e Difusão financiado pela FAPESP e instalado na USP de Ribeirão Preto. O projeto é relacionado às células CAR-T para tratamento de doenças oncológicas -
Treinamento técnico em Comportamento Animal na USP Leste
03 de março de 2020Atividades incluem coleta, organização de dados comportamentais e análise de vídeos de macacos-prego -
Pós-doutorado em Física da Matéria Condensada na Unicamp
03 de março de 2020Projeto que abrigará o bolsista estuda as propriedades físicas da água líquida e do gelo por meio de simulações atomística -
Pós-doutorado em microbiologia do solo no CNPEM
02 de março de 2020Projeto conduzido no Laboratório Nacional de Biorrenováveis visa avaliar impactos da aplicação de diferentes tipos de vinhaça de cana-de-açúcar nas emissões de óxido nitroso e na microbiota funcional do solo -
Pós-doutorado em história de educação matemática na Unifesp
02 de março de 2020Contribuição de Edward Lee Thorndike para o ensino de aritmética será tema do subprojeto a ser desenvolvido pelo bolsista no campus de Guarulhos -
Pós-doutorado em ciência, tecnologia e sociedade na UFSCar
28 de fevereiro de 2020Projeto estuda os desafios e os impactos sociais das embalagens confeccionadas a partir de biopolímeros em toda a cadeia produtiva
Mais lidas do mês
-
Fungo patogênico transmitido pelo arranhão do gato doméstico está presente em animais selvagens
19 de junho de 2026
-
Corpo aproveita pouco os minerais das castanhas, diz estudo que simulou a digestão humana
11 de junho de 2026
-
Homens idosos que dormem mais de nove horas têm maior risco de perder mobilidade
22 de junho de 2026
-
São Paulo terá a primeira usina do país para capturar e armazenar carbono do etanol de cana
11 de junho de 2026
-
Cientistas propõem medidas para conter avanço de fungos resistentes a medicamentos
23 de junho de 2026
-
Relógio inteligente detecta ansiedade e estresse em tempo real
08 de junho de 2026
-
O cientista brasileiro que liderou a digitalização de 400 anos de história da flora do planeta
16 de junho de 2026
-
Pesquisadoras descobrem nova espécie de microrganismo adaptado a frio e calor extremos na Antártida
01 de junho de 2026
-
Estudo detalha como o organismo se adapta a dietas com muita proteína e nenhum carboidrato
15 de junho de 2026
-
Nova técnica identifica estrelas que engoliram planetas
16 de junho de 2026